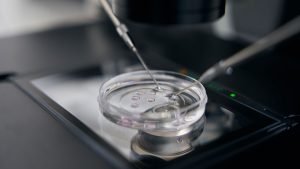

Artigos
Confira aqui todos os posts produzidos pela equipe do escritório VGV Advogados

Médico pode ter agenda separada para convênio e particular? Entenda o que é permitido
A organização da agenda médica é um dos pontos mais sensíveis na gestão do consultório, especialmente quando o profissional atende pacientes de planos de saúde e particulares. Entre médicos, é

Prontuário Médico: o que deve constar, como preencher e por que ele é sua principal defesa profissional
Quando a consulta termina, o cuidado não se encerra. Para o paciente, o tratamento segue. Para o médico, permanece aquilo que sustenta tecnicamente, eticamente e juridicamente toda a assistência prestada:

Como Evitar Processos Ético-Profissionais no CRM: Erros Comuns que Levam Médicos à Denúncia e Como se Proteger
Enfrentar um processo ético-profissional no CRM é uma das maiores preocupações da carreira médica. Após anos de formação, dedicação ao atendimento e construção de reputação, ser alvo de uma denúncia

Seu passado ético pode barrar seu futuro como médico especialista? O risco oculto nos editais das provas de título.
Nos últimos dias, conversei com um médico que teve sua inscrição indeferida na Prova para obtenção de Título de Especialista em Psiquiatria (TEP) – 2025.2. O leitor pode estar imaginando

Fraude na Declaração de Saúde: Quando o Plano Pode Negar Cobertura ou Cancelar o Contrato
A declaração de saúde costuma ser tratada como um simples formulário, preenchido rapidamente no momento da contratação do plano de saúde. No entanto, esse documento tem um peso jurídico muito

Plano de saúde negou internação por carência? Saiba quando a recusa é ilegal
Descobrir que o plano de saúde negou uma internação alegando carência é uma das situações mais angustiantes para pacientes e familiares. Justamente no momento de maior fragilidade, quando a saúde

Do Bisturi ao Banco dos Réus. Uma breve análise sobre a Criminalização da Publicidade Médica e suas armadilhas.
Recentemente, uma sombra jurídica tem gerado apreensão e insegurança em alguns médicos: a ameaça de que a simples divulgação de especialidade médica, sem o devido Registro de Qualificação de Especialista
FGTS para Fertilização In Vitro (FIV): entenda seus direitos e como buscar a liberação judicial
A infertilidade é uma condição médica que afeta milhões de pessoas e pode causar profundo impacto emocional, psicológico e familiar. Para muitos casais, a Fertilização In Vitro (FIV) representa a

Portabilidade de Carência no Plano de Saúde: Quando a Declaração de Saúde é Ilegal
A portabilidade de prazos de carência é um dos principais direitos do consumidor na saúde suplementar. Na prática, ela garante continuidade da cobertura, permitindo que o beneficiário troque de plano

Descredenciamento de Hospital e Clínicas pelo plano de saúde: Direitos do Paciente e Como Agir
A RN 585/2023 da Agência Nacional de Saúde Suplementar (ANS) trouxe mudanças importantes sobre a forma como operadoras devem comunicar o descredenciamento de hospitais, clínicas e serviços de urgência e

Processo Ético-Profissional no CRM: entenda como funciona e como se defender corretamente
O processo ético-profissional é o procedimento por meio do qual os Conselhos Regionais de Medicina avaliam se houve violação ao Código de Ética Médica. Para o médico, é um momento

Junta Médica do Plano de Saúde: quando a negativa de cobertura é ilegal e como agir
A Junta Médica do plano de saúde tornou-se um dos principais instrumentos de contestação das indicações médicas no Brasil. Criada para avaliar procedimentos e materiais cirúrgicos indicados por médicos assistentes,

Plano de Saúde e Autismo (TEA): saiba como garantir seu tratamento completo e ilimitado
Os direitos das pessoas com Transtorno do Espectro Autista (TEA) são frequentemente violados por planos de saúde que negam ou limitam o acesso aos tratamentos multidisciplinares recomendados por médicos e

Transferência dos Beneficiários da Unimed Ferj: o que muda para pacientes e como garantir seus direitos
Entenda a nova mudança na rede Unimed A partir de 20 de novembro de 2025, os 370 mil beneficiários da Unimed Ferj passarão a ser assistidos também pela Unimed do

Cuidado com os falsos especialistas? – Uma segunda provocação. Os pré-requisitos à prova de título como mecanismos de reserva de mercado.
Antecipo que esse texto é uma continuidade do artigo “Cuidado com os falsos especialistas? Uma primeira provocação à hipocrisia do discurso”. Por esse motivo, sugiro sua leitura, antes que o

Cuidado com os falsos especialistas? – Uma primeira provocação à hipocrisia do discurso
Esse texto é o primeiro de uma série que faremos com o objetivo de trazer um pouco de luz ao regramento e aplicação (às vezes, não tão republicana) das normas

A auditoria médica não é área de atuação – Uma crítica ao verniz de legalidade dado a uma prática de reserva de mercado
Esse não é um texto que pretende ser polêmico, apesar do título dar essa impressão. Na medida que você, leitor, for avançando, verá que o texto só pretende ser técnico.

Negativa de Cobertura: Conheça Seus Direitos como Paciente
A negativa de cobertura por planos de saúde é uma situação frustrante e, infelizmente, comum enfrentada por muitos pacientes. Compreender seus direitos e saber como contestar essas negativas é crucial

O Papel dos Prontuários Eletrônicos dos Pacientes na Prática Médica: Importância e Considerações Legais
Os Prontuários Eletrônicos dos Pacientes têm revolucionado a prática médica ao oferecer uma solução digital que facilita o registro, o acesso e a gestão de informações de saúde dos pacientes.

Como a LGPD Impacta a Saúde: Conformidade e Desafios
A Lei Geral de Proteção de Dados (LGPD) entrou em vigor no Brasil com o objetivo de regulamentar a coleta, armazenamento e uso de dados pessoais, impactando significativamente diversos setores,

Nova Resolução do CFM: O que você precisa saber sobre os atos privativos dos médicos
No dia 19/09/2024, o Conselho Federal de Medicina (CFM) publicou a Resolução CFM 2.416, que trata dos atos privativos dos médicos, definindo sua autonomia, responsabilidades e limitações no exercício da

A relação entre médicos e empresas farmacêuticas ante a nova Resolução do CFM
No dia 2 de setembro de 2024, o Conselho Federal de Medicina (CFM) publicou a Resolução CFM 2.386/24, que estabelece diretrizes sobre os vínculos entre médicos e indústrias do setor

A instituição da plataforma Atesta CFM como sistema oficial e obrigatório
O CFM publicou, em 21 de junho de 2024, a Resolução n° 2.382, a qual dispõe sobre a emissão e gerenciamento de atestados médicos físicos e digitais em todo o

STJ reafirma que especialização médica só é exigível na posse em concursos públicos
Em uma decisão recente, o Superior Tribunal de Justiça (STJ) reafirmou um princípio fundamental para concursos públicos na área médica: a comprovação de especialidade médica só pode ser exigida no

O Decreto nº 11.999 de 17 de abril de 2024 e suas repercussões
Desde o dia 18 de abril de 2024 está em vigor o Decreto nº 11.999/2024, que passou a dispor sobre a Comissão Nacional de Residência Médica e sobre o exercício

Médicos formados e registrados não podem ser condenados pelo crime de exercício ilegal da medicina
“Falso psiquiatra é preso em flagrante no município de Terra Santa, no Pará”[1]; “Médica de SC é investigada por atuar como psiquiatra sem especialização”[2]; “Governo contrata médica sem especialização em

Médicos Generalistas e Residentes não poderão mais ser contratados como especialistas em Unidades de Saúde e Hospitais Públicos no estado do Rio de Janeiro
A Proposta de Lei nº 1468-A/2023 de autoria do Deputado Estadual Rodrigo Amorim (União Brasil) foi aprovada na Sessão Ordinária da ALERJ no dia 11.04.2024. A chamada “Lei Moreno Moura”

Decisões em caráter liminar têm garantido o direito de Médicos do Tráfego sem RQE continuarem a atuar, apesar do descredenciamento em âmbito nacional
O cenário previsto por nossos advogados concretizou-se no dia 12 de abril de 2024. A data limite para que todo médico atuante na medicina do tráfego cumprisse os requisitos propostos

Será mesmo que o coordenador de PCMSO deve sempre ter inscrição nos CRMs dos estados nos quais atue?
Uma outra provocação à Resolução CFM nº 2.376, de 18 de janeiro de 2024 A Resolução CFM nº 2.323, de 17 de outubro de 2022 foi criada para regulamentar a

Pode o CFM exigir registro de PCMSO no CRM respectivo?
Uma breve provocação à Resolução CFM nº 2.376/2024 Entenda a nova resolução e seus impactos práticos para empresas e profissionais de saúde. O que a resolução faz? A Resolução CFM

A Revalidação de Certificado Estrangeiro de Residência Médica como um caminho alternativo ao Registro de Qualificação de Especialista (RQE)
Hoje, os médicos têm apenas 2 (dois) caminhos possíveis para conseguir seu Registro de Qualificação de Especialista (RQE) em determinada especialidade médica, quais sejam: É certo que, hoje, o registro

O iminente descredenciamento de mais de 3 mil Médicos do Tráfego em todo o Brasil
Há mais de 20 (anos), a simples conclusão de “Curso de Capacitação para Médico – Perito Examinador Responsável pelo Exame de Aptidão Física e Mental para Condutores de Veículos Automotores”

Inventário Extrajudicial: Simplificando o Processo de Partilha de Bens
Quando um ente querido falece, é natural que os familiares estejam sobrecarregados emocionalmente e enfrentem diversas questões legais relacionadas à partilha dos bens deixados pelo falecido. O processo de inventário,

Inventário e Dívidas do Falecido: O Que Acontece com as Dívidas?
Quando um ente querido falece e deixa um patrimônio, é natural surgir uma preocupação: o que acontece com as dívidas que ele deixou para trás? O processo de inventário envolve

Processo Ético Profissional (PEP): Protegendo a Integridade da Prática Médica
A prática médica está intrinsecamente ligada à ética e à confiança dos pacientes. Quando surgem alegações de má conduta ou violações éticas, entra em jogo o Processo Ético Profissional (PEP).

Defendendo médicos em Processos Éticos-Profissionais (PEP): O papel de um Escritório de Advocacia
Médicos dedicam anos de estudo e trabalho árduo para oferecer cuidados de saúde excepcionais. No entanto, situações podem surgir em que sua conduta ética seja questionada, levando a um Processo

Uma análise do Processo Ético-Profissional (PEP) contra médicos
Em um campo tão crucial quanto a medicina, a ética profissional é de extrema importância. Quando surgem questões de conduta inadequada ou violações éticas por parte de médicos, entra em

Os diretores clínico e técnico de estabelecimentos médicos precisam, necessariamente, possuir Registro de Qualificação de Especialista (RQE)?
Nem sempre. A Resolução CFM nº 2.147/2016 foi publicada com o objetivo de estabelecer normas sobre a responsabilidade, atribuições e direitos de diretores técnicos, diretores clínicos e chefias de serviço

Coordenador (responsável) de PCMSO e médico examinador precisam de RQE em medicina do trabalho para o desempenho das funções?
O objetivo do texto, assim, é compartilhar minhas impressões sobre uma parte da NR-7. A Portaria nº 6.734, de 9 de março de 2020 disciplinou o que se convencionou chamar

Prevenção de erros médicos: promovendo a excelência e a defesa dos médicos
A prevenção de erros médicos é um aspecto crucial para garantir a excelência na prática médica e proteger tanto os pacientes quanto os médicos. Neste artigo, destacaremos a importância da

O papel do advogado especializado em erro médico na busca por justiça
Quando um médico é confrontado com um processo por erro médico, é essencial contar com a orientação e representação de um advogado especializado nessa área. Neste artigo, discutiremos o papel

Conheça os principais tipos de erro médico e seus impactos
O erro médico é uma questão complexa que pode resultar em consequências significativas para os pacientes. Neste artigo, discutiremos os principais tipos de erros médicos e como eles podem impactar

Prêmio de melhor médico? Uma análise sobre a nulidade da Resolução CFM Nº 2.329/2023 e suas repercussões éticas
A Resolução CFM nº 2.329/2023, publicada em 26.01.2023, de acordo com sua ementa, “estabelece as comendas a serem concedidas às personalidades médicas e àqueles que não são médicos”. De início,

Um pouco sobre a história do RQE (Registro de Qualificação de Especialista)
O Registro de Qualificação de Especialista (RQE), originalmente, foi criado pela Resolução CFM nº 734, de 17 de setembro de 1976. Artigo 1º, da Resolução CFM nº 734, de 17

Telessaúde e Medicina do Trabalho
Venho trazer algumas breves reflexões sobre a Lei 14.510/2022 – que autoriza a prática de telessaúde – e suas possíveis repercussões práticas na medicina do trabalho. Logo depois que Projeto

O que fazer ao receber notificação do CRM por infração ética, em um PEP (Processo Ético-Profissional)?
Se você é médico e foi notificado a respeito de um Processo Ético-Profissional (PEP), esse artigo irá lhe dar todas as orientações necessárias para que constitua a sua defesa de

Auxílio moradia para o médico residente: um direito garantido por lei
Se você é médico residente, ou concluiu a residência a menos de cinco anos, e não recebeu o auxílio moradia, é possível obtê-lo judicialmente. Esse artigo irá lhe fornecer todas

O que eu preciso para fazer um inventário [Solução objetiva]
O momento da perda de um ente querido não é fácil. Todavia, faz-se necessário seguir os trâmites legais para que ocorra a justa distribuição dos bens do falecido, e esse

Como diminuir a tributação sobre as consultas médicas – ISS
Se você é médico e integra uma clínica onde apenas médicos atendem, pode ser possível pleitear a redução do ISS. É sobre isso que falaremos nesse artigo. De início, cumpre

Como diminuir o IRPJ e o CSLL de Clínicas Médicas
Este artigo busca falar com você, dono de Clínica Médica, que realiza procedimentos médicos e que hoje está sob o regime tributário de Lucro Presumido. Como você bem sabe, o